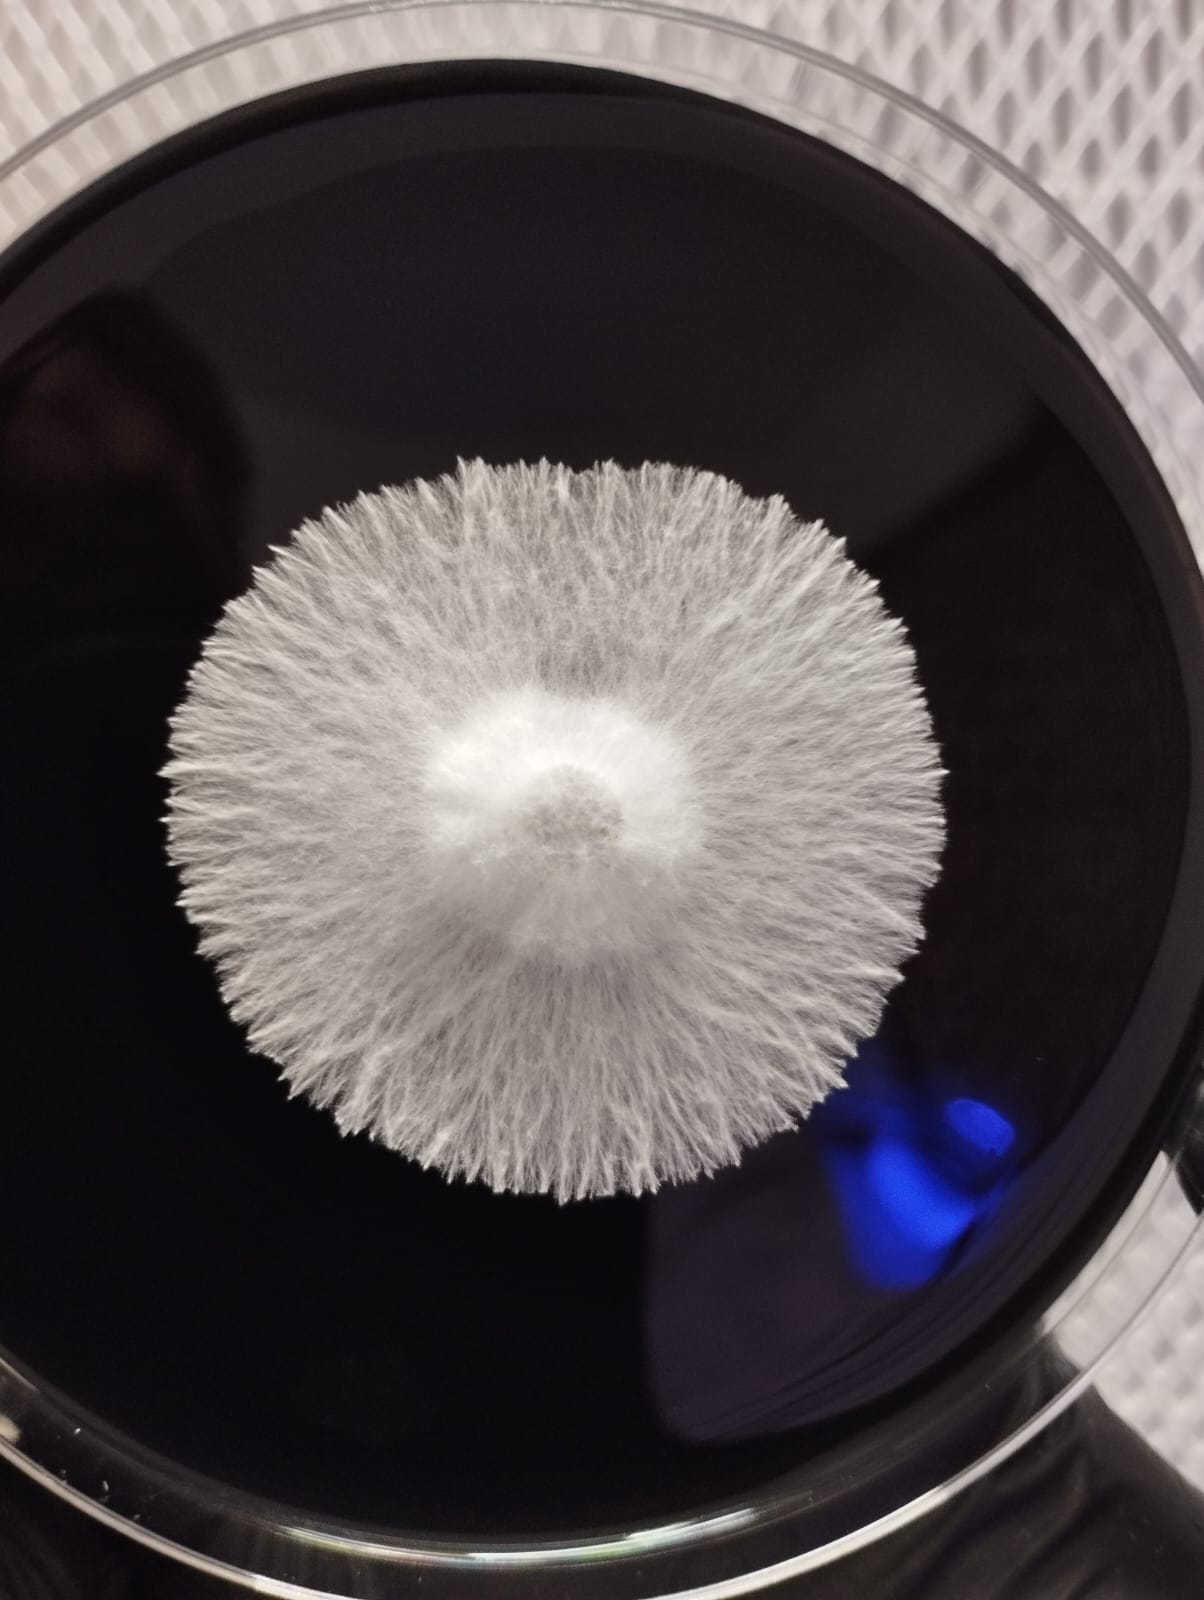

Conoce NuestrosProductos.
Cultivo Liquido
A diferencia de las esporas, el cultivo líquido contiene micelio activo y genéticamente estable, lo que permite una colonización más rápida, uniforme y predecible. Es ideal para inocular granos, sustratos estériles o placas de agar, tanto en cultivos de iniciación como en procesos más controlados.
Cada jeringa se prepara bajo condiciones controladas y se entrega con micelio viable, limpio y en crecimiento activo. Para conservar su calidad, se recomienda mantenerlo refrigerado y manipularlo siempre utilizando técnicas estériles, ya que se trata de un material vivo y sensible.

Placa Petri con Micelio Aislado
Este método permite trabajar con micelio limpio, definido y genéticamente estable, ideal para cultivos más controlados y reproducibles.
Las placas con micelio aislado se utilizan para la propagación del cultivo hacia grano o cultivo líquido, así como para la conservación y evaluación del crecimiento micelial. Al partir de un aislamiento, se reduce la variabilidad y se facilita el control del desarrollo del micelio.
Cada placa se prepara bajo condiciones estériles y se entrega con micelio activo y bien definido. Al tratarse de un material vivo, se recomienda su uso oportuno o su conservación en refrigeración, así como una manipulación cuidadosa utilizando técnicas estériles.
Sello de Esporas
Se utilizan principalmente para trabajos de observación, conservación genética y procesos iniciales de cultivo, permitiendo obtener nuevas combinaciones genéticas y estudiar el desarrollo del micelio desde su origen. A diferencia del micelio ya establecido, las esporas requieren un proceso previo de germinación antes de iniciar su crecimiento.
Cada muestra se obtiene y maneja bajo condiciones controladas para preservar su integridad y viabilidad. Al tratarse de material biológico sensible, se recomienda almacenarlas en un lugar fresco, oscuro y seco, y manipularlas siempre con el debido cuidado.

Grano Colonizado
Este micelio constituye la fase vegetativa del hongo y es el punto de partida para la colonización de sustratos de mayor volumen.
Su uso permite reducir significativamente los tiempos de arranque del cultivo, ya que el micelio se encuentra establecido y en crecimiento. Es ideal para la expansión del cultivo hacia sustratos bulk o para procesos controlados de multiplicación, siempre que se mantengan condiciones adecuadas de higiene y manejo.
Cada unidad se prepara bajo condiciones controladas para asegurar un grano limpio, bien colonizado y con micelio vigoroso. Al tratarse de un material vivo, se recomienda utilizarlo lo antes posible o conservarlo refrigerado, evitando cambios bruscos de temperatura y manipulándolo con técnicas estériles.

AVISO LEGAL
© Hifatec Lab 2026 — Los productos (micelio líquido, suministros, etc…) se ofrecen exclusivamente con fines de investigación, microscopía y taxonomía; no para cultivo de especies restringidas ni consumo humano. Venta restringida a mayores de 18 años.
Hifatec Lab no se hace responsable del uso indebido o destino final de los materiales una vez entregados. Al comprar, el usuario acepta que conoce las leyes locales vigentes en México.
Lee nuestros [Garantia de Servicio] | [Aviso de Privacidad].
¿Dudas? hifateclab@gmail.com o vía WhatsApp.
© Hifatec Lab | Todos los derechos reservados.

